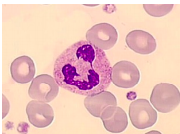

Granulocyte neutrophile en ME
Granulocyte neutrophile en MO

Rein en MO

Muqueuse bronchique en MO

Peau

Epithélium Intestinal en MO

Microvillosités des entérocyte en coupe longitudinal

Microvillosité des entérocyte en coupe tranversale

Pôle LAT des entérocyte et Lymphocyte Intra-épithélial
ME

Pole LAT des entérocytes

Cellules Caliciforme

Epithélium Respiratoire

Coupe transversale de Cil en ME

Glande Unicellulaire : cellule à Mucus

Glande Intra-épithélial

Merocrine

Holocrine

Apocrine

Cellule endocrine sécrétrice de polypeptides

Cellules endocrine sécrétrice de stéroïde

Cellule sécrétrice d’amine biogène